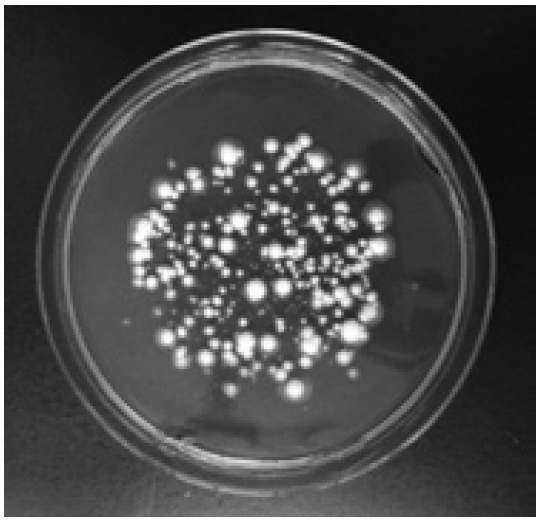

【トピックス】
新規化合物を創製する育種技術の開発
笠原 堅、藤田朋宏
ネオ・モルガン研究所
1. 我々が開発した育種技術"不均衡変異導入法"
人類は、農業・工業・医薬など様々な分野で生物の営みを利用しているが、その利用効率を高めるために、様々な育種技術を開発し産業と文明の発展に役立ててきた。育種技術とは、例えば異なる特徴を併せ持つ生物を生み出すための交雑、突然変異による優良形質獲得を促進するための突然変異導入、求める形質を直接的に付与するための遺伝子組換えなどが挙げられるが、本稿で紹介する不均衡変異導入法とは、突然変異導入法の1つである。
一般に、突然変異を導入する方法としては、物理的にDNAを損傷し変異を導入する方法としての紫外線やX線照射、化学的にDNAを損傷し変異を導入する方法としてのN-メチル-N'-ニトロ-N-ニトロソグアニジン (NTG) やエチルメタンスルホン酸 (EMS) などのアルキル化試薬での処理があげられる。
それに対し不均衡変異導入法は、DNA複製エラーの修復機構を欠失させることで、DNAポリメラーゼによる複製エラーを修復させずに、そのまま変異として蓄積させる生物学的な変異導入法であることが主な特徴である1-3)。不均衡変異導入法を開発するベースとなった不均衡進化理論の提唱者であり進化学者の古澤満は、「DNA複製機構でラギング鎖を複製する役割を担うDNAポリメラーゼδが起こす複製エラーにこそ進化の原動力が潜む。」と主張している4)。我々はこの説に則り、DNAポリメラーセδと連動して働く修復機構を欠失させることにより進化の原動力が活性化された生物を育種に利用し、主に微生物の物質生産性能、物質転換性能の向上で数多くの実績をあげてきた (表1)。
表1 不均衡変異導入法を利用した育種実績 (一部)

2. 天然物創薬 (natural products drug discovery) と醗酵創薬 (fermentation drug design) の違い
医薬領域においても人類は文明の初期から植物や微生物を直接もしくは煎じて摂取することで医薬品として利用してきたが、1920年代にフレミングによってペニシリンが発見され、微生物由来化合物を精製し医薬品として利用する方法が生まれた。この微生物由来化合物を利用した医薬品開発は天然物創薬と呼ばれ、40年代にワックスマンが放線菌由来の抗結核薬ストレプトマイシンを発見したことを端緒に一気に発展した。しかし、90年代前半をピークに、微生物由来新規化合物の単離報告は減少し始め、天然物創薬が衰退しつつあることに警鐘が鳴らされている5)。
こういった天然物創薬の分野において、ほんの十年程前まで育種技術は微生物由来化合物の生産量を増大させる目的のみで利用されてきた。もちろん、近年の分子生物学の発展により、微生物由来化合物の生合成機構が分子レベルで明らかされるようになったことで、遺伝子組換えにより生合成遺伝子を再構築し、新規化合物を獲得しようという試みも多数報告されている6)。しかしながら、遺伝子組換えにより得られた化合物から医薬品として応用できるようなものは未だに得られていないこともあり、生命活動とは無縁の遺伝子組換えによる新規化合物創製技術は、生体に有効な化合物を供給するシステムという点で、長い年月の進化を経て生合成系を構築し化合物を生み出す天然型のプロセスを超えることはできないと考えられるようになってきている。
以上の現状を踏まえ我々は、進化の原動力を活性化する技術“不均衡変異導入法”を用い、有用な化合物を産生するポテンシャルを有する微生物の多様性を拡大することで生体にとって有効な新規化合物を創製するプロセスを開発している。この開発に成功すれば、人類は新規化合物を世界中の極限環境に存在する微生物の中に求めるのではなく、シャーレの中で進化を再現することで進化の結果獲得出来るタイプの新規化合物を得ることが可能になる。微生物が持つ化合物生合成系を醗酵プロセスとして捉え、醗酵プロセスを再構築し創薬シーズとして有用な新規化合物を創製するという意図をもって、我々はこの取り組みを醗酵創薬 (fermentation drug design) と呼んでいる。このコンセプトの元での具体的な研究内容の一部と、これまでに得られた知見について以下で報告する。
3. 醗酵創薬のターゲット 'シクロスポリン生産菌 Tolypocladium inflatum'
醗酵創薬のターゲット微生物として、免疫抑制剤シクロスポリンA (CsA) の生産菌Tolypocladium inflatumを選んだ (図1)。T. inflatumは、1970年代に、ノバルティス ファーマ社の社員が休暇先のノルウェー南部、ハルダンゲル高原から持ち帰った土の中から発見された真菌である7)。同菌の代謝物であるCsAには強い免疫抑制効果があり、臓器移植時の拒絶反応を抑制する医薬品として世界中で使われている。同菌を対象に選んだ理由について、以下説明する。
図1 シクロスポリン生産菌 Tolypocladium inflatum
理由1 得られるシクロスポリン類縁体数の期待値が大きい
シクロスポリン類は、11個のアミノ酸が重合した環状ペプチドである8)。T. inflatumの親株からは、すでに20以上のシクロスポリン類縁体が単離されており、シクロスポリン類を構成するアミノ酸は、通常の20種類以外に、D-アミノ酸やN-メチル化アミノ酸、特殊アミノ酸などが含まれる (表2)8)。構成する11個のアミノ酸のあらゆる組み合わせを想定すると、その数は天文学的な数字になることがわかる。そのシクロスポリンの生合成に関る酵素は、40kbpの巨大な単一遺伝子によってコードされるNon-ribosomal peptide synthase (NRPS) の1種であり、11個のアミノ酸ユニットを重合するために必要な11セットのモジュールから成り立っている (図2)9)。それぞれのモジュールは、condensation domain (C)、adenylation domain (A)、thiolation domain (T) などの機能ドメインで構成されている。最近のNRPSの研究から、Aドメインの1アミノ酸置換が、アミノ酸の選択性に大きな影響を与えることがわかっており10)、不均衡変異導入法を利用したアミノ酸置換により、効率的に各ドメインのアミノ酸選択性を改変し、多様なシクロスポリン類縁体を創製できると考えた。
表2 T. inflatumより単離されているシクロスポリン類8)


図2 シクロスポリン類合成酵素のモジュール及びドメインの配置
理由2 シクロスポリン類は創薬シーズとしての出口の数が多い
CsAは、カルシニューリンを阻害し、免疫抑制作用を示すことが知られている11)。一方で、免疫抑制作用とは独立していると考えられる脳神経細胞保護作用12)など、CsAの生理作用の多様性が以前より注目されていた。2008年になって、免疫抑制とは独立した薬効として腎不全におけるタンパク尿抑制効果が提唱されるなど13)、未だCsAの生理作用の全容は解明されておらず、今後も新たな薬効が見出される可能性も期待できる。
CsAは、イムノフィリンと呼ばれるPPIase (peptidylprolyl cis-trans isomerase) 活性を持ったタンパク質に結合して生理活性を示す。イムノフィリンは、30以上が知られており、それぞれ各種生命維持機構の制御を根幹で担っている。CsAはその内9種のイムノフィリンとの相互作用が確認されており (表3,4)11)、特定のイムノフィリンに結合するシクロスポリン類縁体を取得することが、シクロスポリン類の新規創薬シーズとしての可能性を最大化するアプローチの1つであると考えている。
表3 各種イムノフィリンのカルシニューリン阻害剤感受性

表4 各種イムノフィリンの機能

4.シクロスポリン類縁体のスクリーニング
シクロスポリン類縁体のスクリーニングには、免疫抑制剤に感受性の分裂酵母 its株14)を用いた。its株とは、温度感受性の分裂酵母の中から得られた、カルシニューリン阻害剤に感受性を持つ変異株である。its株は、通常培養時において生育に支障がないが、カルシニューリンの働きが阻害されると致死になる。そこでits株に、各種濃度のCsAを添加した状態で、同its株のCsA感受性を軽減できるサンプルをスクリーニングすると、CsAと拮抗して作用し、且つカルシニューリンを阻害しない化合物をスクリーニングできる。そこから得られる化合物は、CsAと似て非なる化合物、すなわちシクロスポリン類縁体である可能性が高いと期待している。
ここで用いたits株は、Apm1 (µ1 subunit of the clathrin associated adaptor-protein-1 Complex) をコードする遺伝子に変異があり、カルシニューリン阻害剤に感受性がある15)。サンプルは、シクロスポリン類を生産するT. inflatumに不均衡変異導入法を適用し、変異誘導培養、シクロスポリン類生産培養した後、得られた培養菌体のメタノール抽出物を用いた。
スクリーニング結果は、図3に示す通りである。its株に対して致死量のCsAを添加した条件で、its株のCsA感受性を軽減できるサンプルが約1/200の頻度で得られた。いずれのサンプルもCsAを含まない条件では、its株の生育を抑制しているが、CsAの容量に依存して、両者の効果を打ち消し合っていると解釈できる。Apm1は、細胞内小胞輸送に関わるタンパクであり、コロイデレミア・X染色体性非特異的精神遅滞・2B型Charcot-Marie-Tooth病・Carpenter症候群・2型Griscelli症候群などが細胞内小胞輸送に関わる疾患として知られており16)、今回スクリーニングされたサンプルには、これらの症状を緩和する効果を期待している。現在、its株のレスキューに関わる化合物本体を特定する作業を進めている。

図3 CsAとスクリーニングサンプルとの拮抗作用試験
5.おわりに
天然には、アミノ酸ユニット・酢酸ユニット・イソプレンユニットなど、シンプルな代謝物を原料に、多様且つ複雑な化合物を作る生合成システムが多数存在する。今回は、アミノ酸ユニットを連結して環状ポリペプチドを生成するシクロスポリンの生合成系をターゲットにしたが、他にもターゲットはたくさんある。進化の原動力を活性化する不均衡変異導入法を用いることで、微生物由来新規化合物探索のアプローチを、3次元の世界から、過去・未来まで対象を広げた4次元の世界へとターゲット拡張することを目指している。
謝辞
本研究は、神戸大学・久野高義先生より分譲していただいた分裂酵母its株 (Apm1ノックアウト株) を用いて実施しました。深く感謝いたします。
文献
1) Shimoda, C., Itadani, A., Sugino, A., Furusawa, M.: Gen. Genet. Syst., 81, 391 (2006).
2) Itakura, M., Tabata, K., Eda, S., Mitsui, H., Murakami, K., Yasuda, J., Minamisawa, K.: Appl. Environ. Microbiol., 74, 7258 (2008).
3) Abe, H., Takaoka, Y., Chiba, Y., Sato, N., Ohgiya, S., Itadani, A., Hirashima, M., Shimoda, C., Jigami, Y., Nakayama, K.: Glycobiology, 19, 428 (2009).
4) Furusawa, M., Doi, H.: J. Theor. Biol., 157, 127 (1992).
5) 植木正志, 鈴木龍一郎, 長田裕之: バイオインダストリー, 24, 23 (2007).
6) Xue, Q., Ashley, G., Hutchinson, C. R., Santi, D. V.: Proc. Natl. Acad. Sci. USA, 96, 11740 (1999).
7) ノバルティス ファーマ株式会社 Web site: http://www.neoral.jp/medical/medical_01.html
8) Traher, R., Hofmann, H., Loosli, H., Ponelle, M., Wartburg, A.: Helv. Chim. Acta., 70, 13 (1987).
9) ACCESSION ID: CAA82227
10) Rausch, C., Weber, T., Kohlbacher, O., Wohlleben, W., Huson, D. H.: Nucleic Acids Res., 33, 5799 (2005).
11) 高橋信弘: 医薬ジャーナル, 40, 1977 (2004).
12) 芝崎太, 内野博之: 医薬ジャーナル, 40, 2006 (2004).
13) Faul, C., Donnelly, M., Merscher-Gomez, S., Chang, Y. H., Franz, S., Delfgaauw, J., Chang, J., Choi, H. Y., Campbell, K. N., Kim, K., Reiser, J., Mundel, P.: Nat. Med., 14, 931 (2008).
14) 久野高義: 特開2003-9899
15) Sugiura, R., Toda1, T., Shuntoh, H., Yanagida, M., Kuno, T.: EMBO J., 17, 140 (1998).
16) 福田光則: 生体の科学, 59, 360 (2008).